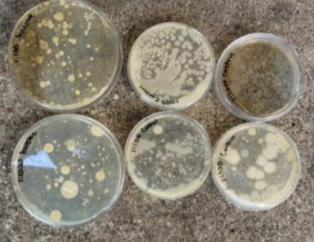

2025 - 2026 RIG
Omni-Directional Gyroscopic Car
The Robotics RIG team is currently investigating the integration of multiple ESP-32 microcontrollers to facilitate complex, synchronized robotic control. This project features the development of an omni-directional remote-controlled (RC) vehicle governed by a sophisticated hand-gesture interface, enabling intuitive navigation through natural physical movement.


Soil Microbiome: Invasive vs Native Flora
This research project focuses on the quantitative measurement and evaluation of how invasive flora alters the Texas rhizosphere. By examining the interplay between plant roots and soil chemistry, the study identifies the specific ways in which non-native species restructure microbial communities compared to those established by native Texas vegetation.

Mav Market
This initiative focuses on the development of a specialized digital ecosystem designed to alleviate the financial and logistical burdens associated with acquiring academic materials. Inspired by the architecture of modern social media and peer-to-peer marketplaces, the platform provides a streamlined, secure environment for student-led resource distribution.


Computer Vision
Navigated Car
This project focuses on the development of an autonomous robotic vehicle capable of real-time environmental perception and targeted navigation. By integrating advanced computer vision with responsive hardware control, the system identifies specific color frequencies and adjusts its movement to interact with detected objects.


